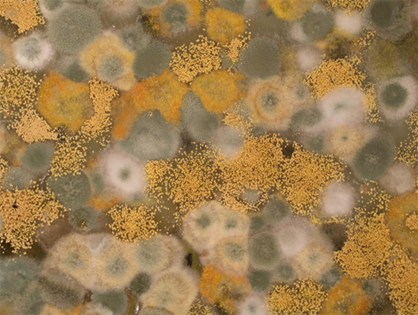

Wenn Sie als Mieter wissen möchten, ob der Schimmel schon vor Ihrem Einzug vorhanden war, ist es oft schwierig, dass ohne eine fachgerechte Untersuchung genau zu bestimmen. Nach mehr als 30 Berufsjahren im Hochbaubereich, kann ich Ihnen als Gutachter für Schäden an Gebäuden mit TÜV Rheinland geprüfter Qualifikation sowie als Sachverständiger für Schimmel- und Feuchteschäden (Prüfung EIPOS Dresden bei Prof. Dr. Constanze Messal) abklären, ob der Schimmel bereits vor Ihrem Einzug vorhanden war oder ob er erst durch falsches Nutzungsverhalten entstanden ist.
Als Vermieter könnten Sie mich ebenfalls gerne im Schadensfalle hinzuziehen, um die Ursache des Schimmelbefalls zu klären. Dabei ist es wichtig zu prüfen, ob der Befall durch bauliche Mängel oder durch falsches Lüften und Heizen entstanden ist.
Wenn ein Schimmelsanierung durchgeführt wurde, sollte der Schimmelbefall deutlich reduziert oder "vollständig" beseitigt sein. Eine abschließende Kontrolle durch einen Fachmann ist empfehlenswert, um sicherzustellen, dass keine Rückstände mehr vorhanden sind und die Feuchtigkeitsprobleme behoben wurden.
Falls Sie weitere Fragen haben oder eine professionelle Begutachtung wünschen, stehe ich Ihnen gerne mit meinem Wissen und meiner Erfahrung zur Verfügung!